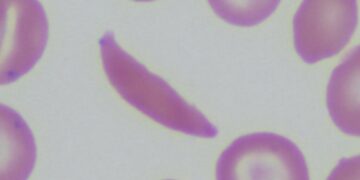
The Hidden Cost Of Sickle Cell

Disease
You can add some category description here.
This is unprecedented. Health officials are currently dealing with a tuberculosis outbreak in the Kansas City metro area, which has...
Read moreDoctors are stunned. A recent clinical trial suggests that people with type 2 diabetes can potentially reverse their condition through...
Read morePatients show signs of brain aging. A study published in JAMA Network Open has revealed that people with sickle cell...
Read moreNew research has come out. A recent review suggests that addressing infections through prevention or treatment might significantly lower the...
Read moreThis will spark industry fears. For the first time, avian influenza has been identified in a commercial poultry farm in...
Read moreDoctors are issuing a warning. A recent study has revealed that people with skin-related lupus have an increased risk of...
Read moreThere is an egg crisis. A major bird flu outbreak has severely impacted U.S. chicken farms, resulting in the deaths...
Read moreIt might be bizarre. A new study suggests that fecal transplants could provide relief for people with type 1 diabetes...
Read moreIt’s a worldwide epidemic. The consumption of sugar-sweetened beverages (SSBs) is responsible for over 2 million new cases of type...
Read moreIt’s a tragic milestone. A person in Louisiana has become the first confirmed death from bird flu in the United...
Read more